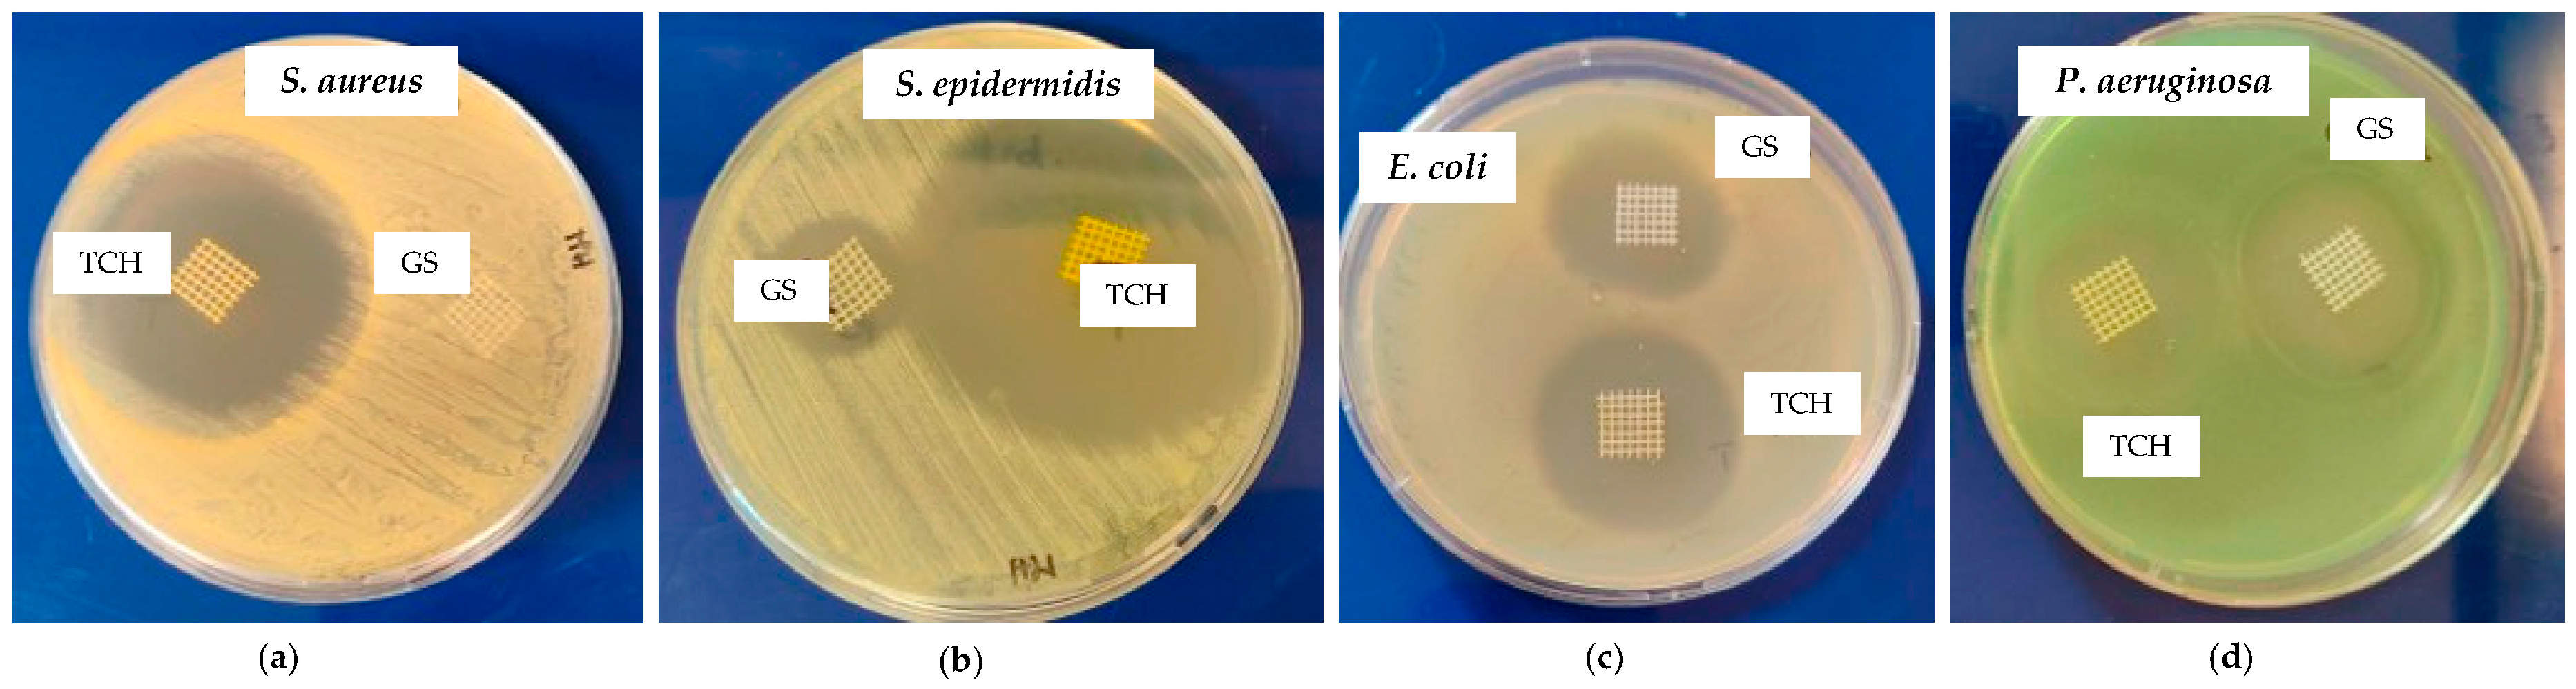
Bioengineering 11 00636 g003 Bioengineering 11 00636 g003

Three-Dimensional Melted Electrowriting Drug Coating Fibers for the Prevention of Device-Associated Infections: A Pilot Study
Abstract
1. Introduction
2. Materials and Methods
2.1. MEW Printing of Medical-Grade PCL Meshes
2.2. Preparation of Meshes Loaded with TCH and GS
2.3. FTIR Analysis of the PCL-TCH and PCL-GS Meshes
2.4. In Vitro Microbiological Assays
2.4.1. Zone Inhibition Assay
2.4.2. Bacterial Biofilm Assays
2.5. Scanning Electron Microscopy (SEM)
2.6. Statistical Analysis
3. Results
3.1. Preparation of Meshes Loaded with TCH and GS
3.2. In Vitro Microbiological Assays
3.2.1. Zone Inhibition Assay
3.2.2. Bacterial Biofilm Assays
4. Discussion
5. Conclusions
Author Contributions
Funding
Institutional Review Board Statement
Informed Consent Statement
Data Availability Statement
Acknowledgments
Conflicts of Interest
References
- Dadi, N.C.T.; Radochová, B.; Vargová, J.; Bujdáková, H. Impact of Healthcare-Associated Infections Connected to Medical Devices—An Update. Microorganisms 2021, 9, 2332. [Google Scholar] [CrossRef] [PubMed]
- Olsen, T.; Jørgensen, O.D.; Nielsen, J.C.; Thøgersen, A.M.; Philbert, B.T.; Johansen, J.B. Incidence of device-related infection in 97 750 patients: Clinical data from the complete Danish device-cohort (1982–2018). Eur. Heart J. 2019, 40, 1862–1869. [Google Scholar] [CrossRef] [PubMed]
- von Eiff, C.; Jansen, B.; Kohnen, W.; Becker, K. Infections associated with medical devices: Pathogenesis, management and prophylaxis. Drugs 2005, 65, 179–214. [Google Scholar] [CrossRef] [PubMed]
- Sikora, A.; Farah, Z. Nosocomial Infections; StatPearls Publishing: Treasure Island, FL, USA, 2023. [Google Scholar]
- Andersson, D.I. Persistence of antibiotic resistant bacteria. Curr. Opin. Microbiol. 2003, 6, 452–456. [Google Scholar] [CrossRef] [PubMed]
- Khatoon, Z.; McTiernan, C.D.; Suuronen, E.J.; Mah, T.-F.; Alarcon, E.I. Bacterial biofilm formation on implantable devices and approaches to its treatment and prevention. Heliyon 2018, 4, e01067. [Google Scholar] [CrossRef]
- Wi, Y.M.; Patel, R. Understanding Biofilms and Novel Approaches to the Diagnosis, Prevention, and Treatment of Medical Device-Associated Infections. Infect. Dis. Clin. North Am. 2018, 32, 915–929. [Google Scholar] [CrossRef] [PubMed]
- Loveday, H.P.; Wilson, J.A.; Pratt, R.J.; Golsorkhi, M.; Tingle, A.; Bak, A.; Browne, J.; Prieto, J.; Wilcox, M. epic3: National Evidence-Based Guidelines for Preventing Healthcare-Associated Infections in NHS Hospitals in England. J. Hosp. Infect. 2007, 86, S1–S70. [Google Scholar] [CrossRef]
- Habash, M.; Reid, G. Microbial Biofilms: Their Development and Significance for Medical Device—Related Infections. J. Clin. Pharmacol. 1999, 39, 887–898. [Google Scholar] [CrossRef] [PubMed]
- Viola, G.M.; Rosenblatt, J.; Raad, I.I. Drug eluting antimicrobial vascular catheters: Progress and promise. Adv. Drug Deliv. Rev. 2017, 112, 35–47. [Google Scholar] [CrossRef]
- Mathew, E.; Domínguez-Robles, J.; Stewart, S.A.; Mancuso, E.; O’Donnell, K.; Larrañeta, E.; Lamprou, D.A. Fused Deposition Modeling as an Effective Tool for Anti-Infective Dialysis Catheter Fabrication. ACS Biomater. Sci. Eng. 2019, 5, 6300–6310. [Google Scholar] [CrossRef]
- Karimi, A.; Rahmatabadi, D.; Baghani, M. Various FDM Mechanisms Used in the Fabrication of Continuous-Fiber Reinforced Composites: A Review. Polymers 2024, 16, 831. [Google Scholar] [CrossRef] [PubMed]
- Bhardwaj, N.; Kundu, S.C. Electrospinning: A fascinating fiber fabrication technique. Biotechnol. Adv. 2010, 28, 325–347. [Google Scholar] [CrossRef]
- Wendorff, J.H.; Agarwal, S.; Greiner, A. Electrospinning: Materials, Processing, and Applications; Wiley: Hoboken, NJ, USA, 2012. [Google Scholar]
- Dalton, P.D.; Vaquette, C.; Farrugia, B.L.; Dargaville, T.R.; Brown, T.D.; Hutmacher, D.W. Electrospinning and additive manufacturing: Converging technologies. Biomater. Sci. 2013, 1, 171–185. [Google Scholar] [CrossRef]
- Dalton, P.D. Melt electrowriting with additive manufacturing principles. Curr. Opin. Biomed. Eng. 2017, 2, 49–57. [Google Scholar] [CrossRef]
- Dalton, P.D.; Grafahrend, D.; Klinkhammer, K.; Klee, D.; Möller, M. Electrospinning of polymer melts: Phenomenological observations. Polymer 2007, 48, 6823–6833. [Google Scholar] [CrossRef]
- Cho, Y.W.; Park, J.H.; Kim, S.H.; Cho, Y.; Choi, J.M.; Shin, H.J.; Bae, Y.H.; Chung, H.; Jeong, S.Y.; Kwon, I.C. Gentamicin-releasing urethral catheter for short-term catheterization. J. Biomater. Sci. Polym. Ed. 2003, 14, 963–972. [Google Scholar] [CrossRef]
- Matsuda, T.; Kawahara, D. Electrospinning fabrication of high-trackable catheter tip with gradually graded or gradient flexibility. J. Biomed. Mater. Res. B Appl. Biomater. 2008, 87, 35–41. [Google Scholar] [CrossRef]
- Yadav, S.; Arya, D.K.; Pandey, P.; Anand, S.; Gautam, A.K.; Ranjan, S.; Saraf, S.A.; Rajamanickam, V.M.; Singh, S.; Chidambaram, K.; et al. ECM Mimicking Biodegradable Nanofibrous Scaffold Enriched with Curcumin/ZnO to Accelerate Diabetic Wound Healing via Multifunctional Bioactivity. Int. J. Nanomed. 2022, 17, 6843–6859. [Google Scholar] [CrossRef] [PubMed]
- Ali, S.; Khatri, Z.; Oh, K.W.; Kim, I.S.; Kim, S.H. Preparation and characterization of hybrid polycaprolactone/cellulose ultrafine fibers via electrospinning. Macromol. Res. 2014, 22, 562–568. [Google Scholar] [CrossRef]
- Ezhilarasu, H.; Ramalingam, R.; Dhand, C.; Lakshminarayanan, R.; Sadiq, A.; Gandhimathi, C.; Ramakrishna, S.; Bay, B.H.; Venugopal, J.R.; Srinivasan, D.K. Biocompatible Aloe vera and Tetracycline Hydrochloride Loaded Hybrid Nanofibrous Scaffolds for Skin Tissue Engineering. Int. J. Mol. Sci. 2019, 20, 5174. [Google Scholar] [CrossRef]
- Haroosh, H.J.; Dong, Y.; Lau, K.A. Tetracycline hydrochloride (TCH)-loaded drug carrier based on PLA:PCL nanofibre mats: Experimental characterisation and release kinetics modelling. J. Mater. Sci. 2014, 49, 6270–6281. [Google Scholar] [CrossRef]
- Arakkal, A.; Sirajunnisa, P.; Sailaja, G.S. Natural rubber latex films with effective growth inhibition against S. aureus via surface conjugated gentamicin. J. Bioact. Compat Polym. 2023, 38, 220–233. [Google Scholar] [CrossRef]
- Cavalu, S.; Roiu, G.; Pop, O.; Heredea, D.A.P.; Costea, T.O.; Costea, C.F. Nano-Scale Modifications of Amniotic Membrane Induced by UV and Antibiotic Treatment: Histological, AFM and FTIR Spectroscopy Evidence. Materials 2021, 14, 863. [Google Scholar] [CrossRef] [PubMed]
- da Cunha, M.N.B.; Rynkevic, R.; da Silva, M.E.T.; Moreira da Silva Brandão, A.F.; Alves, J.L.; Fernandes, A.A. Melt Electrospinning Writing of Mesh Implants for Pelvic Organ Prolapse Repair. 3D Print. Addit. Manuf. 2021, 9, 389–398. [Google Scholar] [CrossRef] [PubMed]
- Soares, Í.; Faria, J.; Marques, A.C.F.; Ribeiro, I.A.C.; Baleizão, C.; Bettencourt, A.F.; Ferreira, I.M.M.; Baptista, A.C. Drug Delivery from PCL/Chitosan Multilayer Coatings for Metallic Implants. ACS Omega 2022, 7, 23096–23106. [Google Scholar] [CrossRef] [PubMed]
- Berthomieu, C.; Hienerwadel, R. Fourier transform infrared (FTIR) spectroscopy. Photosynth Res. 2009, 101, 157–170. [Google Scholar] [CrossRef] [PubMed]
- Gaffney, J.S.; Marley, N.A.; Jones, D.E. Fourier Transform Infrared (FTIR) Spectroscopy. Charact. Mater. 2012, 1–33. [Google Scholar]
- Chang, H.-I.; Perrie, Y.; Coombes, A.G.A. Delivery of the antibiotic gentamicin sulphate from precipitation cast matrices of polycaprolactone. J. Control. Release 2006, 110, 414–421. [Google Scholar] [CrossRef] [PubMed]
- Gimeno, M.; Pinczowski, P.; Pérez, M.; Giorello, A.; Martínez, M.Á.; Santamaría, J.; Arruebo, M.; Luján, L. A controlled antibiotic release system to prevent orthopedic-implant associated infections: An in vitro study. Eur. J. Pharm. Biopharm. 2015, 96, 264–271. [Google Scholar] [CrossRef]
- Grossman, T.H. Tetracycline Antibiotics and Resistance. Cold Spring Harb Perspect. Med. 2016, 6, a025387. [Google Scholar] [CrossRef]
- Dong, C.-L.; Li, L.-X.; Cui, Z.-H.; Chen, S.-W.; Xiong, Y.Q.; Lu, J.-Q.; Liao, X.-P.; Gao, Y.; Sun, J.; Liu, Y.-H. Synergistic Effect of Pleuromutilins with Other Antimicrobial Agents against Staphylococcus aureus In Vitro and in an Experimental Galleria mellonella Model. Front. Pharmacol. 2017, 8, 553. [Google Scholar] [CrossRef] [PubMed]
- Piras, A.M.; Maisetta, G.; Sandreschi, S.; Gazzarri, M.; Bartoli, C.; Grassi, L.; Esin, S.; Chiellini, F.; Batoni, G. Chitosan nanoparticles loaded with the antimicrobial peptide temporin B exert a long-term antibacterial activity in vitro against clinical isolates of Staphylococcus epidermidis. Front. Microbiol. 2015, 6, 372. [Google Scholar] [CrossRef] [PubMed]
- Oduor, J.M.; Bw’Onkoba, N.; Maloba, F.; Arodi, O.; Nyachieo, A. Efficacy of lytic Staphylococcus aureus bacteriophage against multidrug-resistant Staphylococcus aureus in mice. J. Infect. Dev. Ctries. 2016, 10, 1208–1213. [Google Scholar] [CrossRef] [PubMed]
- Arapović, J.; Kompes, G.; Dedi, K.; Teskeredžić, S.; Ostojić, M.; Travar, M.; Tihić, N.; Delić, J.; Skočibušić, S.; Zekiri-Sivro, M.; et al. Antimicrobial resistance profiles of human Brucella melitensis isolates in three different microdilution broths: First multicentre study in Bosnia and Herzegovina. J. Glob. Antimicrob. Resist. 2022, 29, 99–104. [Google Scholar] [CrossRef] [PubMed]
- Sekiguchi, J.-I.; Asagi, T.; Miyoshi-Akiyama, T.; Fujino, T.; Kobayashi, I.; Morita, K.; Kikuchi, Y.; Kuratsuji, T.; Kirikae, T. Multidrug-resistant Pseudomonas aeruginosa strain that caused an outbreak in a neurosurgery ward and its aac (6’)-Iae gene cassette encoding a novel aminoglycoside acetyltransferase. Antimicrob. Agents Chemother. 2005, 49, 3734–3742. [Google Scholar] [CrossRef][Green Version]
- Kumar B, A.; Thankappan, B.; Jayaraman, A.; Gupta, A. Evaluation of Antibiotic Tolerance in Pseudomonas aeruginosa for Aminoglycosides and Its Predicted Gene Regulations through In-Silico Transcriptomic Analysis. Microbiol. Res. 2021, 12, 630–645. [Google Scholar] [CrossRef]

| Temperature (°C) | Voltage (kV) | Nozzle’s Height (mm) | Collector’s Speed (mm/min) |
|---|---|---|---|
| 200 | 7.0 | 3.0 | 700 |
| S. aureus | S. epidermidis | E. coli | P. aeruginosa | |
|---|---|---|---|---|
| Control | 0 mm | 0 mm | 0 mm | 0 mm |
| PCL-TCH | 20 ± 2 mm | 24 ± 4 mm | 12 ± 3 mm | 5 ± 1 mm |
| PCL-GS | 0 mm | 7 ± 2 mm | 8 ± 2 mm | 15 ± 3 mm |
Disclaimer/Publisher’s Note: The statements, opinions and data contained in all publications are solely those of the individual author(s) and contributor(s) and not of MDPI and/or the editor(s). MDPI and/or the editor(s) disclaim responsibility for any injury to people or property resulting from any ideas, methods, instructions or products referred to in the content. |
© 2024 by the authors. Licensee MDPI, Basel, Switzerland. This article is an open access article distributed under the terms and conditions of the Creative Commons Attribution (CC BY) license (https://creativecommons.org/licenses/by/4.0/).
Share and Cite
Martins, J.P.; da Silva, E.T.; Fernandes, A.A.; Costa de Oliveira, S. Three-Dimensional Melted Electrowriting Drug Coating Fibers for the Prevention of Device-Associated Infections: A Pilot Study. Bioengineering 2024, 11, 636. https://doi.org/10.3390/bioengineering11070636
Martins JP, da Silva ET, Fernandes AA, Costa de Oliveira S. Three-Dimensional Melted Electrowriting Drug Coating Fibers for the Prevention of Device-Associated Infections: A Pilot Study. Bioengineering. 2024; 11(7):636. https://doi.org/10.3390/bioengineering11070636
Chicago/Turabian StyleMartins, Joana P., Elisabete T. da Silva, António A. Fernandes, and Sofia Costa de Oliveira. 2024. "Three-Dimensional Melted Electrowriting Drug Coating Fibers for the Prevention of Device-Associated Infections: A Pilot Study" Bioengineering 11, no. 7: 636. https://doi.org/10.3390/bioengineering11070636
APA StyleMartins, J. P., da Silva, E. T., Fernandes, A. A., & Costa de Oliveira, S. (2024). Three-Dimensional Melted Electrowriting Drug Coating Fibers for the Prevention of Device-Associated Infections: A Pilot Study. Bioengineering, 11(7), 636. https://doi.org/10.3390/bioengineering11070636

